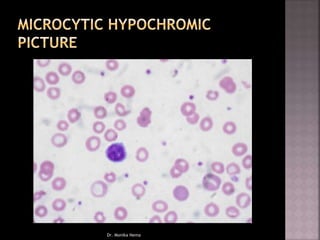
Dr. Monika Nema
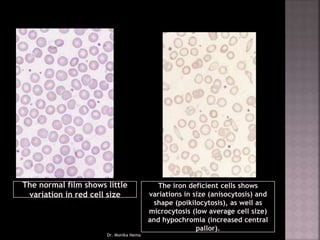
The normal film shows little
variation in red cell size
The iron deficient cells shows
variations in size (anisocytosis) and
shape (poikilocytosis), as well as
microcytosis (low average cell size)
and hypochromia (increased central
pallor).
Dr. Monika Nema
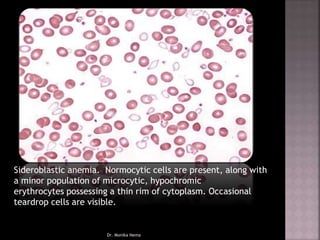
Sideroblastic anemia. Normocytic cells are present, along with
a minor population of microcytic, hypochromic
erythrocytes possessing a thin rim of cytoplasm. Occasional
teardrop cells are visible.
Dr. Monika Nema
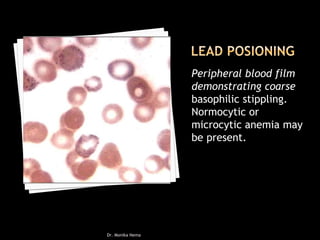
Peripheral blood film
demonstrating coarse
basophilic stippling.
Normocytic or
microcytic anemia may
be present.
Dr. Monika Nema

Microcytic anemia is characterized by reduced oxygen delivery due to a decrease in red blood cells and hemoglobin levels. It is most commonly linked to iron deficiency and presents with symptoms such as fatigue and pallor, often diagnosed through a complete blood count. Various causes include chronic blood loss, inadequate iron intake, and genetic disorders like thalassemia.